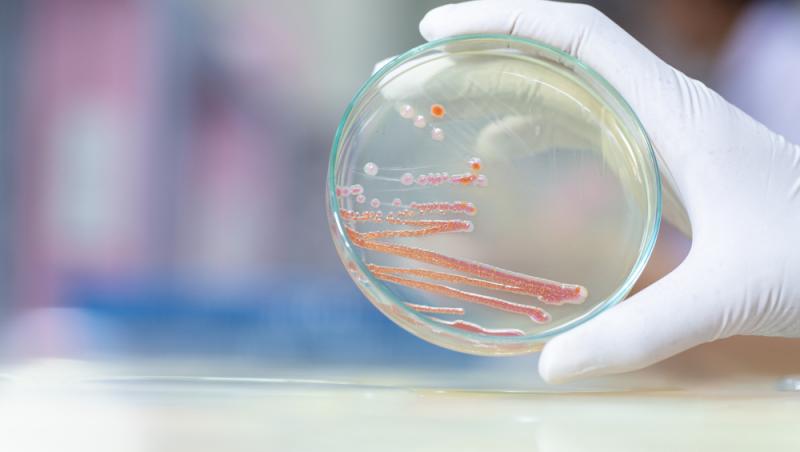

Focarul de infecții nosocomiale de la Spitalul de Copii „Sf. Maria” din Iași i-a îngrozit pe români după ce șase copii internați la secția de Terapie Intensivă (ATI) și-au pierdut viața în ultimele zile în urma infectării cu bacteria Serratia Marcescens.
Potrivit Direcției de Sănătate Publică (DSP) Iași, în incinta spitalului există și alți pacienți diagnosticați cu aceeași bacterie, aflându-se sub supraveghere medicală, iar Ministerul Sănătății amenință cu demiteri, trimițând Corpul de Control la fața locului.
Citește și: Care sunt simptomele de ciumă bubonică. Boala nu a fost eradicată, sunt 7 cazuri pe an în SUA
Descoperă în rândurile de mai jos cât de periculoasă este această bacterie și de ce au fost aplicate sancțiuni în cazul instituției.
Ce este bacteria Serratia Marcescens, responsabilă de tragediile de la Spitalul de Copii „Sfânta Maria” din Iași
Serratia Marcescens este o bacterie care face parte din familia Enterobacteriacae și care poate deveni extrem de periculoasă, mai ales atunci când cei care o contactează au imunitatea foarte scăzută.
Potrivit Observator News, aceasta este un bacil Gram-negativ, izolat de rutină din sânge și din plăgi pe medii de cultură precum agar-sânge, dar și din tractul respirator sau urinar, utilizând medii selective precum agar MacConkey sau agar cromogen.
Deși inițial nu a fost considerată o bacterie cu relevanță patogenă, se pare că în prezent este asociată des cu infecțiile nosocomiale, afectând în special pacienții spitalizați pe termen lung și care au imunitatea compromisă.
Citește și: Top 5 cele mai frecvente tipuri de cancer din România și simptomele lor
Infecțiile cauzate de această bacterie apar în general în secțiile de terapie intensivă, acolo unde pacienții trec prin anumite proceduri invazise precum intubații, catetere sau dializă, deoarece este ușurată pătrunderea microbului în organism.
„Este o bacterie care, inițial, când a fost descoperită acum 150 de ani, era considerată banală, saprofită. Ulterior s-a constatat că produce mai ales în cazul pacienților care au și alte afecțiuni, așa-numitele infecții nosocomiale, și produce fie infecții urinare, rezistente la tratament, pentru că bacteria a devenit între timp și multi rezistentă la tratament. Dar sunt și cazuri în care se răspândește și poate să producă sepsis sau septicemie.
Problema legată de această bacterie este că este rezistentă în mediu, se găsește mai ales la nivelul instalațiilor sanitare, care trebuie curățate foarte bine cu produse pe bază de clor, ca să elimine sau să reducă riscul de infecție” a declarat fostul ministru al Sănătății, Alexandru Rafila, pentru Observator, după ce cazul focarului de infecții nosocomiale de la Spitalul de Copii „Sf. Maria” din Iași a cutremurat întreaga țară.
Potrivit Ministerului Sănătății, prima infecție din spital ar fi apărut pe data de 13 septembrie, însă a fost raportată cu întârziere către DSP, timp în care au mai apărut încă trei cazuri.
Instituția susține că spitalul nu a aplicat la timp măsurile de izolare și nici nu a transmis raportările așa cum prevede legea, motiv pentru care în cele din urmă s-a ajuns la 9 pacienți infectați, dintre care 6 au decedat.
Potrivit Adevărul, Ministrul Sănătății, Alexandru Florin Rogobete, a anunțat că au fost aplicate deja primele sancțiuni. Acestea sunt:
- amendă în valoare de 10 000 de lei pentru medicul epidemiolog pentru nerespectarea prevederilor legale în controlul infecțiilor nosocomiale
- amendă în valoare de 10 000 de lei pentru medicul ATI pentru nerespectarea protocoalelor
- amendă în valoare de 50 000 de lei pentru conducerea spitalului pentru nerespectarea protocoalelor
„Dacă este necesar, cu siguranță, voi demite atât directorul DSP Iași, cât și directorul unității medicale din Iași. (...) Și sigur toate persoanele implicate vor fi sancționate corespunzător. Este inacceptabil ca într-un Spital de Pediatrie aceste situații să nu fie raportate și să nu fie luate măsurile specifice în anul 2025.(...) Cei care nu și-au făcut treaba vor pleca acasă”,”, a declarat Alexandru Florin Rogobete, potrivit sursei citate anterior.